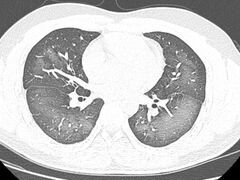

党的十八大以来,以习近平同志为核心的党中央高度重视体育强国建设,始终把人民健康放在优先发展的位置,将全民健身纳入国家战略,推动全民健身和全民健康深度融合。 少年强中国强,体育强中国强。如今,越来越多的青少年积极投身于各项体育运动,在锻炼中释放能量。 提升竞技体育综合实力,是体育强国建设的战略任务之一。近年来,竞技体育捷报频传,各类赛事接连举办,体育健儿“圈粉”无数,为建设体育强国作出贡献。 在全国
2023-08-07 16:16
新华社
连日来,受台风“杜苏芮”影响,华北、东北等地出现极端降雨过程,引发洪涝和地质灾害。 面对罕见洪涝灾害,以习近平同志为核心的党中央坚强领导、有力指挥,多地紧急动员、团结奋战,强化救灾安置和生产生活恢复,全力打好防汛抢险和受灾群众保障攻坚战。 8月6日,北京受降雨影响的50多条公交线路恢复运行,受灾区域的防疫消杀工作全面启动;房山、门头沟、昌平地区供电受影响的270个村接近六成恢复供电。河北涿州已有9
2023-08-07 16:06
央视新闻
2023-08-07 15:35
四川应急
2023-08-07 15:29
自贡网
2023-08-07 15:27
自贡网
2023-08-07 15:25
自贡网
2023-08-07 15:23
自贡网
夏日炎炎, 正是需要防晒的时候。 市场上的防晒产品琳琅满目, 因为使用起来方便又有清凉感, 防晒喷雾, 成了近几年的网红产品。 近日, 湖南长沙一位小伙, 因使用防晒喷雾不当, 竟给自己带来了不小的麻烦! 视频来源:潇湘晨报 使用防晒喷雾时误吸 20岁小伙检竟查出“白肺” 日前,20岁的长沙小伙李林(化名)在外出前使用了防晒喷雾,在对着面部喷洒时一不小心误吸,随即出现胸闷、咳嗽的症状。症状一直持
2023-08-07 14:10
钱江晚报
新华社成都8月6日电(记者吴光于)八月成都,热情似火。第31届世界大学生夏季运动会开幕以来,“青春、团结、友谊”的故事每天都在赛场内外上演。成都的公园中、街巷里,芙蓉花已从枝叶中探出花骨朵,美丽的花儿在岁月更迭中凝视城市繁华,谛听青春欢歌,点缀盛会斑斓。 成都市花——芙蓉花。成都武侯区委宣传部供图 芙蓉花开 “蓉光”绽放 “四十里城花发时,锦囊高下照坤维。”五代后蜀时期,成都诗人张立描绘了芙蓉花开
2023-08-07 14:04
新华社
核心提示: 山东德州市平原县发生5.5级地震 震源深度10千米 中国地震台网正式测定:08月06日02时33分在山东德州市平原县(北纬37.16度,东经116.34度)发生5.5级地震,震源深度10千米。 8月6日9时45分 受地震影响,途经石济客专部分列车停运 受山东省德州市平原县发生5.5级地震影响,8月6日途经石济客专(石家庄至济南)的D1661次、D1621次、G375次、D1611次、G
2023-08-06 11:03
央视新闻客户端
近期,不少iphone手机用户纷纷收到“奇怪”的短信,信息为iMessage形式发送,短信内容不堪入目。 这类信息主要是因为用户iCloud账户遭遇泄露,不法分子获取了账户名单,通过iMessage批量群发。 最后一般会附上一条链接 千!万!别!点 点开就是上当的第一步 不法分子以色情内容为诱饵 附上网址链接群发钓鱼短信 一旦点击钓鱼链接 手机可能会被植入木马 窃取个人银行卡号、手机号 验证码等个
2023-08-06 07:26
公安部网安局
川观新闻记者 卢薇 8月4日,中国人民银行成都分行召开2023年下半年工作会议。会议透露,2023年初以来,四川融资总量保持稳定增长,截至6月末,全省社会融资规模同比增长13.4%,高于全国4.4个百分点;各项贷款突破10万亿元,同比增长14.8%,高于全国4.2个百分点,已经连续11个月居全国前三位。 金融支持经济恢复发展精准有效。在抓好重大项目融资保障方面,政策性开发性金融工具已签约项目支付率
2023-08-06 07:15
川观新闻
8月5日,省委书记王晓晖在成都会见生态环境部部长黄润秋一行。双方围绕深入贯彻习近平总书记来川视察重要指示精神、全面落实全国生态环境保护大会部署,就进一步深化部省合作、持续深入打好污染防治攻坚战、加快推动发展方式绿色低碳转型、助力美丽四川建设等交换了意见。 省领导陈炜、胡云,生态环境部有关司局和省直有关部门负责同志等参加。 川观新闻记者 张守帅
2023-08-05 23:13
川观新闻
时政热点,“+”速解读。 【编者按】“中华民族历来讲求‘天下一家’,主张民胞物与、协和万邦、天下大同,憧憬‘大道之行,天下为公’的美好世界。”千百年来,“世界大同、天下一家”始终是中华民族的理想追求。习近平主席汲取中华优秀传统文化思想精华,多次提及“天下一家”观点,为世界人民求和平、谋发展贡献中国智慧、中国方案。央视网《联播+》推出《天下一家》系列报道,与您一同感受习主席胸怀天下的情怀与担当。 联
2023-08-05 20:50
央视网
8月3日凌晨2点10分,最后一批滞留北京门头沟区安家庄站、落坡岭站的乘客抵达北京丰台站。至此,因暴雨被困的K396次、K1178次、Z180次列车所有滞留旅客安全疏运完毕。 截至目前,门头沟、房山、昌平等受灾区域通讯电力逐步恢复、道路陆续打通、受灾群众得到妥善安置,灾后重建正在抓紧开展…… 刚过去的几天里,北京遭遇历史罕见汛情—— 7月29日20时至8月2日7时,北京出现极端强降雨天气,降雨量为北
2023-08-05 20:48
新华社
连日来,我省各市州召开会议,传达学习习近平总书记来川视察重要指示精神,研究贯彻落实意见。各地表示,要深刻领会总书记重要指示精神的丰富内涵、核心要义和实践要求,确保总书记的重要指示要求在四川落地生根、开花结果。 泸州市委常委会召开(扩大)会议强调,要深入实施高质量发展“八大行动”和高品质生活“八大工程”;要加快融入成渝地区双城经济圈建设。主动服务国家战略,深入推进经济区与行政区适度分离改革,深化与重
2023-08-05 20:45
四川观察
8月5日,三星堆博物馆发布暑期参观提示,内容如下: 各位游客朋友: 真诚感谢大家长期以来对我馆的关注与厚爱!三星堆博物馆新馆(陈列馆)试运行期间适逢暑期,持续迎来参观高峰。据监测统计,每天预约门票点击量超过130万次。我馆采取了优化预约方式、调整放票时间、增加预约名额等措施,但仍然难以满足观众的参观热情。为方便广大观众来馆参观,三星堆博物馆特此温馨提示: 一、自2023年7月30日起,我馆门票放票
2023-08-05 15:01
三星堆博物馆
天府融媒·封面新闻记者伍勇 杨芮雯摄影报道 简阳文体中心游泳馆内,观众台上,随着动感音乐,有人微微摇摆,有人拍照纪念,氛围轻松。 此前,8块金牌已被中国队以大比分领先收入囊中,让观众一度认为今天的比赛仍然会被轻松拿下。 谁也不会料到,随后的混合双人10米跳台决赛赛况会如此令人焦灼。 8月4日,成都大运会跳水项目第9块金牌争夺战,中国选手王彬翰与王伟莹出场,全场欢呼。 排在第一位出场,王彬翰与王伟莹
2023-08-05 12:28
封面新闻
天府融媒·四川观察 许乐柠 郭帷 你们知道最近的“集章热”吗?成都大运会期间,不少网友都晒出了自己的盖章“成绩”,大运纪念章吸引了一大波市民游客收集打卡,今天观观就带大家去解锁“集大运纪念章”的快乐。 25枚成都大运会纪念章,不仅包含了18枚运动项目纪念章,图案设计采用了成都大运会发布的官方体育图标“十八墨宝”,憨萌又灵动,还有5枚大运主题章、1枚大运村章和1枚主媒体中心章,全部免费盖!在熊猫邮局
2023-08-05 12:27
四川观察
天府融媒·四川新闻网 记者 张宇 8月4日下午,成都大运会召开大运遗产专场发布会。 发布会现场成都大运会执委会办公室专职副主任曹雪峰在会上表示,大运会场馆后续利用的问题是从筹办之初就开始关注和思考的一个问题。 “在过去几年的筹备过程中,我们始终注重场馆的公益性与经营性、社会效益与经济效益之间的关系,将举办重大赛事与全民健身充分结合起来,推动赛事的承载功能和群众的健身功能同步配置,既满足群众日益增长
2023-08-05 12:27
四川新闻网Copyright © 2006-2024 WWW.ZGM.CN 自贡网 All Rights Reserved. 自贡日报社 主办
地址:四川省自贡市汇川路1240号自贡报业大楼 电话:0813-8220769 8220773 邮箱:webmaster@zgm.cn
互联网新闻信息服务许可证编号:51120190016 蜀ICP备11013724号 川公网安备51030002000105号
信息网络传播视听节目许可证编号:1-23-3-2-0008
涉本网站网络内容从业人员违法违规行为举报电话:0813-8220769 网络内容从业人员违法违规行为举报
涉未成年人投诉举报电话:0813-8220770 电子邮箱:wcn@zgm.cn | 涉互联网算法推荐专项举报渠道
中国互联网举报中心举报电话: 12377 | 涉本网站违法和不良信息举报电话:0813-8220770 | 涉企举报专区
食品安全投诉举报电话:0813-2988060 电子邮箱:zgsscjgjyjk@163.com
